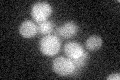
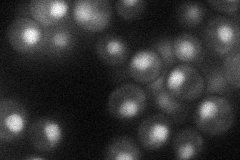
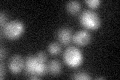

View description
Component of the U1 snRNP complex required for pre-mRNA splicing; putative ortholog of human U1C protein, which is involved in formation of a complex between U1 snRNP and the pre-mRNA 5' splice site
Localization:
Intensity:
Fold change:
Significance:
-
C’ GFP library in SD
below threshold16.86 -
N' NOP1pr-GFP in SD
nucleus33.7685 -
N' TEF2pr-mCherry in SD

nucleus7.34572 -
N' NATIVEpr-GFP in SD

nucleus25.614 -
N' TEF2pr-VC and Cyto-VN in SD

below threshold24.0053 -
C’ GFP library in SD+DTT
cytosol17.211.02No -
C’ GFP library in SD+H2O2

cytosol15.220.9No -
C’ GFP library in Starvation Media

cytosol15.360.91No -
C’ GFP library on the background of Pup2-DaMP

N/A -
C’ GFP library on the background of CCT mutant

N/A0N/AYes
